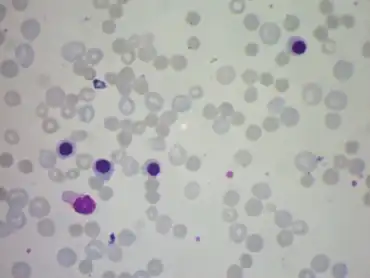

Evans syndrome
| Evans syndrome | |
|---|---|
Evans syndrome is an autoimmune disease in which an individual's immune system attacks their own red blood cells and platelets, the syndrome can include immune neutropenia.[1][2] These immune cytopenias may occur simultaneously or sequentially.[1][3]
Its overall phenotype resembles a combination of autoimmune hemolytic anemia and immune thrombocytopenic purpura.[1][4][5] Autoimmune hemolytic anemia is a condition in which the red blood cells that normally carry oxygen are destroyed by an autoimmune process. Immune thrombocytopenic purpura is a condition in which platelets are destroyed by an autoimmune process. Platelets are a component of blood that contribute to the formation of blood clots in the body to prevent bleeding.
The syndrome was first described in 1951 by R. S. Evans and colleagues.[1]
Signs and symptoms
The symptoms of Evans syndrome vary between patients depending on which blood cells are affected. If red blood cells are attacked, symptoms may include weakness and fatigue, paleness or jaundice, shortness of breath, lightheadedness, and/or a fast heartbeat. If platelets are attacked, symptoms may include increased bruising, prolonged nosebleeds, increased bleeding from minor cuts, and/or Petechiae. In the less common instance that white blood cells are attacked, symptoms may include increased proneness to infection, fevers, and/or mouth sores.[6][7]
It has been variously reported that between 7.8%[4] and 23%[8] of patients who have autoimmune hemolytic anemia, will also have thrombocytopenia and thus Evans syndrome. The two cytopenias may occur together or sequentially.[1][3][9]
Causes
Although Evans syndrome seems to be a disorder of immune regulation, the exact pathophysiology is unknown, but a gradual loss of self-tolerance is postulated.[5] Autoantibodies targeted at different antigenic determinants on red cells and platelets are assumed to cause isolated episodes of hemolytic anemia and thrombocytopenia, respectively.[10]
Diagnosis
Diagnosis of Evans syndrome is separated into primary and secondary presentation. There is no single test to confirm a diagnosis of either form of Evans syndrome. It is instead a diagnosis made after a thorough clinical history, documentation of common symptoms, clinical evaluation, and exclusion of all other possible conditions.[1]
The diagnosis of primary Evans syndrome is made upon blood tests to confirm not only hemolytic anemia and immune thrombocytopenic purpura, but also a positive direct antiglobulin test (DAT) and an absence of any known underlying cause.[3] Additional tests used to eliminate the possibility of other conditions include a computed tomography (CT) scan and a biopsy of bone marrow.[1]
A diagnosis of secondary Evans syndrome is indicative of occurrence after another autoimmune disease is already present.[11] In 27% to 50% of cases there is an associated malignancy or a predisposing autoimmune disease.[4][5][12] Pre-existing autoimmune diseases can include autoimmune lymphoproliferative syndrome (ALPS), combined variable immunodeficiency (CVID), systemic autoimmune disease, or another disorder of immune dysregulation.[13]
Other antibodies may occur directed against neutrophils and lymphocytes,[14] and "immunopancytopenia" has been suggested as an alternative term for this syndrome.[15]
Treatment
Initial treatment is with glucocorticoid corticosteroids or intravenous immunoglobulin, a treatment that is also used in ITP cases.[5][16][17] In children, it can remain well controlled with a long term immunosuppressant therapy that will occasionally lead to a spontaneous complete resolution of the condition.[18] Although the majority of cases initially respond well to treatment, relapses are not uncommon[3][5] and immunosuppressive drugs[3][5] (e.g. ciclosporin,[19][20] mycophenolate mofetil, vincristine[21] and danazol[22]) are subsequently used,[3] or combinations of these.[23]
The off-label use of rituximab (trade name Rituxan) has produced some good results in acute and refractory cases,[3][5][24][25] although further relapse may occur within a year.[3] Splenectomy is effective in some cases,[26] but relapses are not uncommon.[27]
The only prospect for a permanent cure is the high-risk option of an allogeneic hematopoietic stem cell transplantation (SCT).[28][29]
Prognosis
In a nationwide study of Evans syndrome the median survival was 7.2 years (primary Evans syndrome: 10.9 years; secondary Evans syndrome: 1.7 years). Secondary Evans syndrome was associated with higher mortality rate than primary Evans syndrome, with a 5-year survival of 38%. Among patients with Evans syndrome, the prevailing causes of death were bleeding, infections, and hematological cancer.[4]
It has been observed that there is a risk of developing other autoimmune problems and hypogammaglobulinemia,[30] in one cohort 58% of children with Evans syndrome had CD4-/CD8- T cells which is a strong predictor for having autoimmune lymphoproliferative syndrome.[31]
Epidemiology
Evans syndrome is considered a very rare autoimmune disease. Only one study has estimated incidence and prevalence adults. In Denmark in 2016 the annual incidence was 1.8 per 1,000,000 person years, and the prevalence was 21.3 per 1,000,000 living persons.[4] In pre-pubertal children the incidence has been estimated to be between 0.7 and 1.2 per 1,000,000 person-years.[32][33]
See also
References
- 1 2 3 4 5 6 7 "Evans Syndrome". NORD (National Organization for Rare Disorders). Archived from the original on 2022-03-15. Retrieved 2022-03-15.
- ↑ "Evans syndrome". Genetic and Rare Diseases Information Center. Archived from the original on 2021-08-11. Retrieved 2018-04-17.
- 1 2 3 4 5 6 7 8 Norton A, Roberts I (2006). "Management of Evans syndrome". Br. J. Haematol. 132 (2): 125–37. doi:10.1111/j.1365-2141.2005.05809.x. PMID 16398647. S2CID 7633446.
- 1 2 3 4 5 Hansen DL; Möller S; Andersen K; Gaist D; Frederiksen H (2019). "Evans syndrome in adults - incidence, prevalence, and survival in a nationwide cohort" (PDF). Am J Hematol. 94 (10): 1081–1090. doi:10.1002/ajh.25574. PMID 31292991. S2CID 195879785. Archived (PDF) from the original on 2021-08-28. Retrieved 2022-07-27.
- 1 2 3 4 5 6 7 Michel M; Chanet V; Dechartres A; Morin A-S; Piette J-C; Cirasino L; Emilia G; Zaja F; Ruggeri M; Andrès E; Bierling P; Godeau B; Rodeghiero F (2009). "The spectrum of Evans syndrome in adults: new insight into the disease based on the analysis of 68 cases". Blood. 114 (15): 3167–3172. doi:10.1182/blood-2009-04-215368. PMID 19638626.
- ↑ "Evans syndrome | Genetic and Rare Diseases Information Center (GARD) – an NCATS Program". rarediseases.info.nih.gov. Archived from the original on 2021-08-11. Retrieved 2020-11-27.
- ↑ "Evans Syndrome | Symptoms & Causes | Boston Children's Hospital". www.childrenshospital.org. Archived from the original on 2020-11-25. Retrieved 2020-11-27.
- ↑ Cai JR, Yu QZ, Zhang FQ (1989). "[Autoimmune hemolytic anemia: clinical analysis of 100 cases]". Zhonghua Nei Ke Za Zhi (in 中文). 28 (11): 670–3, 701–2. PMID 2632179.
- ↑ Ng SC (1992). "Evans syndrome: a report on 12 patients". Clinical and Laboratory Haematology. 14 (3): 189–93. doi:10.1111/j.1365-2257.1992.tb00364.x. PMID 1451398.
- ↑ "EVANS SYNDROME". 2019-10-22. Archived from the original on 2022-06-15. Retrieved 2022-07-27.
{{cite journal}}: Cite journal requires|journal=(help) - ↑ Despotovic, Jenny M, ed. (2018). Immune Hematology | SpringerLink (PDF). doi:10.1007/978-3-319-73269-5. ISBN 978-3-319-73268-8. S2CID 46891351.
- ↑ "Evans syndrome". Genetic and Rare Diseases Information Center. Archived from the original on 2021-08-11. Retrieved 2019-07-28.
- ↑ Despotovic, Jenny M, ed. (2018). Immune Hematology | SpringerLink (PDF). doi:10.1007/978-3-319-73269-5. ISBN 978-3-319-73268-8. S2CID 46891351.
- ↑ Pegels JG, Helmerhorst FM, van Leeuwen EF, van de Plas-van Dalen C, Engelfriet CP, von dem Borne AE (1982). "The Evans syndrome: characterization of the responsible autoantibodies". Br. J. Haematol. 51 (3): 445–50. doi:10.1111/j.1365-2141.1982.tb02801.x. PMID 7104228.
- ↑ Pui CH, Wilimas J, Wang W (1980). "Evans syndrome in childhood". J. Pediatr. 97 (5): 754–8. doi:10.1016/S0022-3476(80)80258-7. PMID 7191890.
- ↑ Nuss R, Wang W (1987). "Intravenous gamma globulin for thrombocytopenia in children with Evans syndrome". The American Journal of Pediatric Hematology/Oncology. 9 (2): 164–7. doi:10.1097/00043426-198722000-00012. PMID 2438958. S2CID 19749102.
- ↑ Mehta JB, Singhal SB, Mehta BC (1992). "Intravenous immunoglobulin therapy of idiopathic thrombocytopenia". The Journal of the Association of Physicians of India. 40 (5): 340–2. PMID 1483999.
- ↑ "Evan's Syndrome". Boston Children's Hospital. Archived from the original on 2020-12-01. Retrieved 2020-11-23.
- ↑ Emilia G, Messora C, Longo G, Bertesi M (1996). "Long-term salvage treatment by cyclosporin in refractory autoimmune haematological disorders". Br. J. Haematol. 93 (2): 341–4. doi:10.1046/j.1365-2141.1996.4871026.x. PMID 8639426. S2CID 11724766.
- ↑ Liu H, Shao Z, Jing L (2001). "[The effectiveness of cyclosporin A in the treatment of autoimmune hemolytic anemia and Evans syndrome]". Zhonghua Xue Ye Xue Za Zhi (in 中文). 22 (11): 581–3. PMID 11855146.
- ↑ Yokoyama K; Kojima M; Komatsumoto S; et al. (1992). "[Thrombotic thrombocytopenic purpura achieving complete remission by slow infusion of vincristine]". Rinsho Ketsueki (in 日本語). 33 (8): 1084–9. PMID 1404865.
- ↑ Koike M; Ishiyama T; Saito K; et al. (1993). "[Effective danazol therapy for a patient with Evans syndrome]". Rinsho Ketsueki (in 日本語). 34 (2): 143–6. PMID 8492411.
- ↑ Scaradavou A, Bussel J (1995). "Evans syndrome. Results of a pilot study utilizing a multiagent treatment protocol". J. Pediatr. Hematol. Oncol. 17 (4): 290–5. doi:10.1097/00043426-199511000-00003. PMID 7583383. S2CID 20968070.
- ↑ Zecca M; Nobili B; Ramenghi U; et al. (15 May 2003). "Rituximab for the treatment of refractory autoimmune hemolytic anemia in children". Blood. 101 (10): 3857–61. doi:10.1182/blood-2002-11-3547. PMID 12531800.
- ↑ Shanafelt TD, Madueme HL, Wolf RC, Tefferi A (November 2003). "Rituximab for immune cytopenia in adults: idiopathic thrombocytopenic purpura, autoimmune hemolytic anemia, and Evans syndrome" (PDF). Mayo Clin. Proc. 78 (11): 1340–6. doi:10.4065/78.11.1340. PMID 14601692. Archived from the original (PDF) on 2006-03-13. Retrieved 2007-04-18.
- ↑ Hamidah A, Thambidorai CR, Jamal R (2005). "Prolonged remission after splenectomy for refractory Evans syndrome--a case report and literature review". Southeast Asian J. Trop. Med. Public Health. 36 (3): 762–4. PMID 16124452.
- ↑ Mathew P, Chen G, Wang W (1997). "Evans syndrome: results of a national survey". J. Pediatr. Hematol. Oncol. 19 (5): 433–7. doi:10.1097/00043426-199709000-00005. PMID 9329465. S2CID 24014798.
- ↑ Martino R, Sureda A, Brunet S (1997). "Peripheral blood stem cell mobilization in refractory autoimmune Evans syndrome: a cautionary case report". Bone Marrow Transplant. 20 (6): 521. doi:10.1038/sj.bmt.1700924. PMID 9313889.
- ↑ Oyama Y, Papadopoulos EB, Miranda M, Traynor AE, Burt RK (2001). "Allogeneic stem cell transplantation for Evans syndrome". Bone Marrow Transplant. 28 (9): 903–5. doi:10.1038/sj.bmt.1703237. PMID 11781654.
- ↑ Wang WC (1988). "Evans syndrome in childhood: pathophysiology, clinical course, and treatment". The American Journal of Pediatric Hematology/Oncology. 10 (4): 330–8. doi:10.1097/00043426-198824000-00013. PMID 3071168. S2CID 20125761.
- ↑ Teachey DT; Manno CS; Axsom KM; et al. (2005). "Unmasking Evans syndrome: T-cell phenotype and apoptotic response reveal autoimmune lymphoproliferative syndrome (ALPS)". Blood. 105 (6): 2443–8. doi:10.1182/blood-2004-09-3542. PMID 15542578.
- ↑ Mannering N; Hansen DL; Frederiksen H (2020). "Evans syndrome in children below 13 years of age - A nationwide population-based cohort study". PLOS ONE. 15 (4): e0231284. Bibcode:2020PLoSO..1531284M. doi:10.1371/journal.pone.0231284. PMC 7145102. PMID 32271826.
- ↑ Aladjidi N; Fernandes H; Leblanc T; Vareliette A; Rieux-Laucat F; Bertrand Y; Chambost H; Pasquet M; Mazingue F; Guitton C; Pellier I; Roqueplan-Bellmann F; Armari-Alla C; Thomas C; Marie-Cardine A; Lejars O; Fouyssac F; Bayart S; Lutz P; Piguet C; Jeziorski E; Rohrlich P; Lemoine P; Bodet D; Paillard C; Couillault G; Millot F; Fischer A; Pérel Y; Leverger G (2015). "Evans Syndrome in Children: Long-Term Outcome in a Prospective French National Observational Cohort". Front Pediatr. 3 (79): e0231284. doi:10.3389/fped.2015.00079. PMC 7145102. PMID 32271826.
External links
| Classification | |
|---|---|
| External resources |